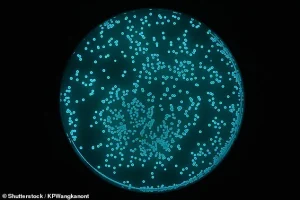
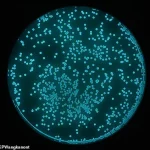

In a world where screens dominate childhood and toys often end up forgotten in the back of a closet, a team of scientists has introduced a radical new concept: the ‘organic Tamagotchi,’ a living, glowing toy that demands constant care.

Dubbed SquidKid, the device is not a digital simulation but a miniature bioreactor filled with bioluminescent bacteria that children must keep alive.
Unlike the pixelated pets of the 1990s, this toy requires real-world responsibility, from feeding it to ensuring it gets enough oxygen and agitation.
The result?
A glowing, pulsating creature that rewards its caretakers with a mysterious shimmer if tended to properly.
The inspiration for SquidKid comes from the Hawaiian bobtail squid, a marine creature that shares a symbiotic relationship with bioluminescent bacteria.
These bacteria live in a specialized organ within the squid’s body, producing light that helps the animal avoid predators by camouflaging its shadow.
The toy replicates this natural phenomenon using Vibrio fischeri, the same type of bacteria found in the squid. ‘It’s a living, breathing version of a bioreactor,’ explained Deirdre Ni Chonaill, a researcher at Northeastern University who helped develop the toy. ‘Kids don’t always treat their toys very well.
With Tamagotchi, there are times where if you ignored it, it died.
In this case, you’re actually killing something.’
The toy’s design is both simple and ingenious.
A squeezable tentacle pumps air into the water, ensuring the bacteria receive the oxygen they need to survive.
The bacteria, in turn, produce light when agitated, creating a visual reward for the child’s efforts.

This interplay between care and consequence mirrors the challenges of maintaining a real bioreactor, where conditions like temperature, food, and agitation must be meticulously controlled. ‘In a brewery, tanks are heated to the right temperatures for yeast to convert sugars into alcohol,’ Ni Chonaill noted. ‘But here, we’re giving kids a toy version of that process, one they can keep going for a long time.’
Despite its educational potential, SquidKid is unlikely to win over germaphobes.
The toy’s reliance on living bacteria raises questions about safety and contamination.
While Vibrio fischeri is not pathogenic and poses no risk of infection, the warm, nutrient-rich environment inside the toy could potentially be hijacked by other microorganisms. ‘There’s always a chance of contamination,’ Ni Chonaill admitted. ‘But we’ve taken precautions to minimize that risk, just like in real bioreactors.’ The team has emphasized that the bacteria used are non-harmful and that the toy is designed to be a closed system, reducing the likelihood of unwanted microbial growth.

For parents and educators, SquidKid represents a unique opportunity to introduce children to the complexities of biology and environmental science.
By requiring daily interaction, the toy fosters a sense of responsibility and curiosity. ‘It’s not just about keeping a pet alive,’ Ni Chonaill said. ‘It’s about understanding the delicate balance of life, the importance of oxygen, food, and agitation.
It’s a hands-on lesson in microbiology.’
Yet, the toy’s success may depend on its ability to balance education with entertainment.
While some may see it as a novel way to engage children with science, others might find the idea of nurturing living bacteria in a toy unsettling.
Still, for those willing to embrace the challenge, SquidKid offers a glimpse into the future of interactive learning—one where the line between play and science becomes increasingly blurred.
During the development of SquidKid, a biotech toy inspired by the symbiotic relationship between the Hawaiian bobtail squid and its glowing bacterial partners, researchers faced unexpected challenges.
Early experiments with bacterial colonies led to a ‘disastrous’ incident where the team had to use an electron microscope to confirm that their microbes were free from contamination by E. coli.
This discovery was a wake-up call, as even though most E. coli strains are harmless to humans, some can cause severe gastrointestinal issues, raising concerns about the safety of a toy intended for children.
The team behind SquidKid, however, insists that these issues have been resolved.
By implementing strict biosecurity protocols and isolating the bacterial cultures, they claim that the toy’s microbes are now safe from unwanted infections.
The result is a living, glowing toy that children can care for, learning about bacterial growth, bioengineering, and the delicate balance of symbiosis in nature. ‘SquidKid is not only microbiology,’ said Katia Zolotovsky, assistant professor of Design and Biotechnology at Northeastern University. ‘It’s also teaching kids how to take care of the environment and then learn biology, mutualism, and environmental interdependence.’
The toy’s design mimics the Hawaiian bobtail squid’s natural ability to emit light through a symbiotic relationship with bacteria.
When properly maintained, the bacteria in SquidKid produce a ghostly blue glow, which children can activate by squeezing a tentacle to inject oxygen.
This interactive feature not only makes the toy visually captivating but also serves as a hands-on lesson in microbial biology.
The researchers hope that SquidKid will inspire a new generation of scientists to explore the intricate connections between organisms and their environments.
Despite its potential, SquidKid remains a prototype.
It was recognized for its innovative approach with the Outstanding Display prize at the 2025 Biodesign Challenge, but there are currently no plans to commercialize the toy.
This isn’t the first time the Tamagotchi concept has been reimagined for educational or behavioral purposes.
For instance, the Sleepagotchi, a digital pet that requires users to get enough rest to keep it happy, aims to gamify healthy habits.
In contrast, the ‘Vape-o-Gotchi’—a darker twist on the idea—links an e-cigarette to a virtual pet that dies if the user stops vaping, with its creators joking that the concept was ‘kind of funnier to be evil.’
While these toys reflect the growing intersection of technology and education, they also raise questions about the ethical implications of using gamification to influence behavior.
Experts caution that while tools like Sleepagotchi can promote positive habits, the Vape-o-Gotchi highlights the risks of normalizing harmful behaviors through interactive media.
As biotechnology and interactive design continue to evolve, the challenge lies in ensuring that such innovations prioritize public well-being without compromising ethical standards.
The story of SquidKid underscores the delicate balance between scientific curiosity and responsibility.
By turning a complex biological process into an engaging toy, the team hopes to spark interest in microbiology and environmental science.
Yet, as with any product involving living organisms, the emphasis on safety, transparency, and long-term impact remains critical.
Whether SquidKid becomes a household name or remains a prototype, its development reflects a broader trend: the increasing role of interdisciplinary innovation in shaping how society interacts with science and technology.